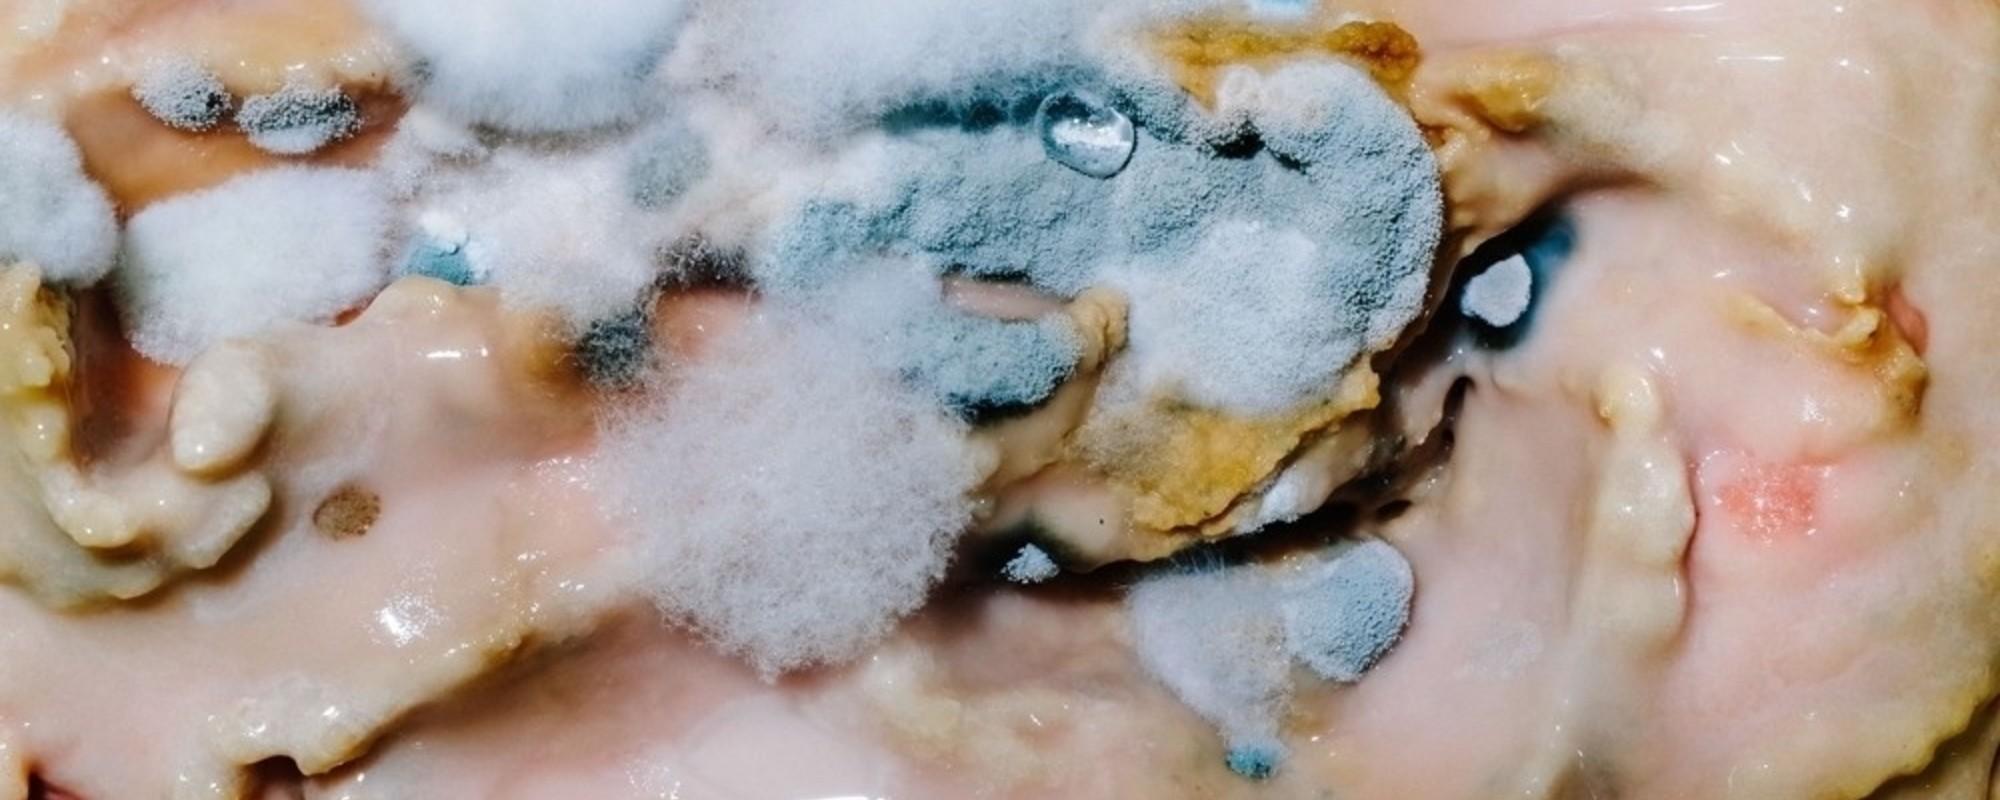

Je suis né en france et je vis en cote d'ivoire j'aimerai intégrer la légion française étrangère.
Comment puis je le faire puisque je ne réside pas sur le sol français?
Le 08/09/2015 à 15h11 j'ai 19ans résidant en cote d'ivoire et j'aimerai entrer dans la légion étrangère. comment dois j'faire le 11/03.
La légion étrangère dénombre, parmi ses quelque 9 000 hommes, 90% d’étrangers et 148 nationalités.
11% des légionnaires sont francophones, cette part étant majoritairement constituée de français.
Cet article revient sur le béaba de l’apprentissage de la langue française à.
Bonjour, si vous ne possédez pas la nationalité française, la légion etrangère est la seule option pour intégrer l'armée de terre.
Si vous souhaitez vous engager dans la légion etrangère, vous devez obligatoirement vous rendre en france par vos propres moyens et vous présenter à un centre de recrutement de la légion etrangère.
La légion étrangère est un corps de l' armée de terre française disposant d'un commandement particulier et comportant plusieurs subdivisions d'arme :
Infanterie, cavalerie, génie et troupes aéroportées.
La légion est également indépendante du point de vue de son recrutement 1.
Créée en 1831 pour permettre l'incorporation de.
Voici la liste des conditions à remplir pour s'engager dans la légion étrangère :
Vous devez être âgé entre 17,5 ans et 39,5 ans le jour de la présentation au poste d’information (la moyenne d'âge du recrutement est de 23 ans !), savoir au minimum lire et écrire dans la langue maternelle.
C’est en effet le seul corps de l’ armée française qui reçoit en son sein les soldats étrangers.
La légion constitue une force de frappe et un atout pour la france.
Quel est votre profil d’emploi.
Le jour de votre arrivée au poste d’information de la légion étrangère, vous devez être apte médicalement à effectuer les tests d’aptitude physique.
Être apte physiquement à servir en tous lieux, en tous temps et sans restriction.
Indice de masse corporelle d.
Bonjour ,mon pseudonyme est demiderosh50,j'aimerai intégrer la légion étrangère française,mais je suis en cote d'ivoire.
Alors s'il vous plaît, dite moi comment faire pour y intégrer. merci.
Comment intégrer la légion.
L'armée de terre recrute et forme toute l'année.
Préparation pour intégrer la le en tant qu'étranger.
Par jinoka, 17 décembre 2018 dans légion étrangère.
Les étrangers comme les français peuvent intégrer la légion étrangère.
La seule condition est d’apporter une carte d’identité ou un passeport en cours de validité au moment du recrutement.
Aujourd’hui, près de 150 nationalités composent.
Institution unique au monde, la légion étrangère est une unité prestigieuse intégrée à l’armée de terre.
Depuis près de deux siècles, les légionnaires ont participé aux plus grandes.
Voir les discussions entre les candidats et nos soldats.
Vie quotidienne (121) notre culture (3) pourquoi nous (175) autre… candidatures (497) progression de carrière (350) conseils de carrière (314) conseils sur l'éligibilité (2254) conseils d'entretien (141) diversité (138) rôle.
On ne peut pas intégrer la légion étrangère si on est une femme ou à n’importe quel âge.
Il faut être un homme âgé entre 17 ans et demi et.
De mère française et d un père ivoirien moi kassé djanhouet kan gerard ludovic sans un manque d apathie je désire integré la legion étrangère française. je rappel que je suis agé de 26 ans et comme diplôme un bts en ressource humaine et communication. l on pourra me contacte au numeroo suivant +22547717655.
A ce titre la condition physique du légionnaire est très importante pour la capacité opérationnelle, il en va de la vie même de ses camarades.
Afin de bien se préparer, le major gérald vous donne des conseils simples d’emploi et de bon sens :
Pour cela une chaîne youtube est à votre disposition.
Playlist des entrainements du major.